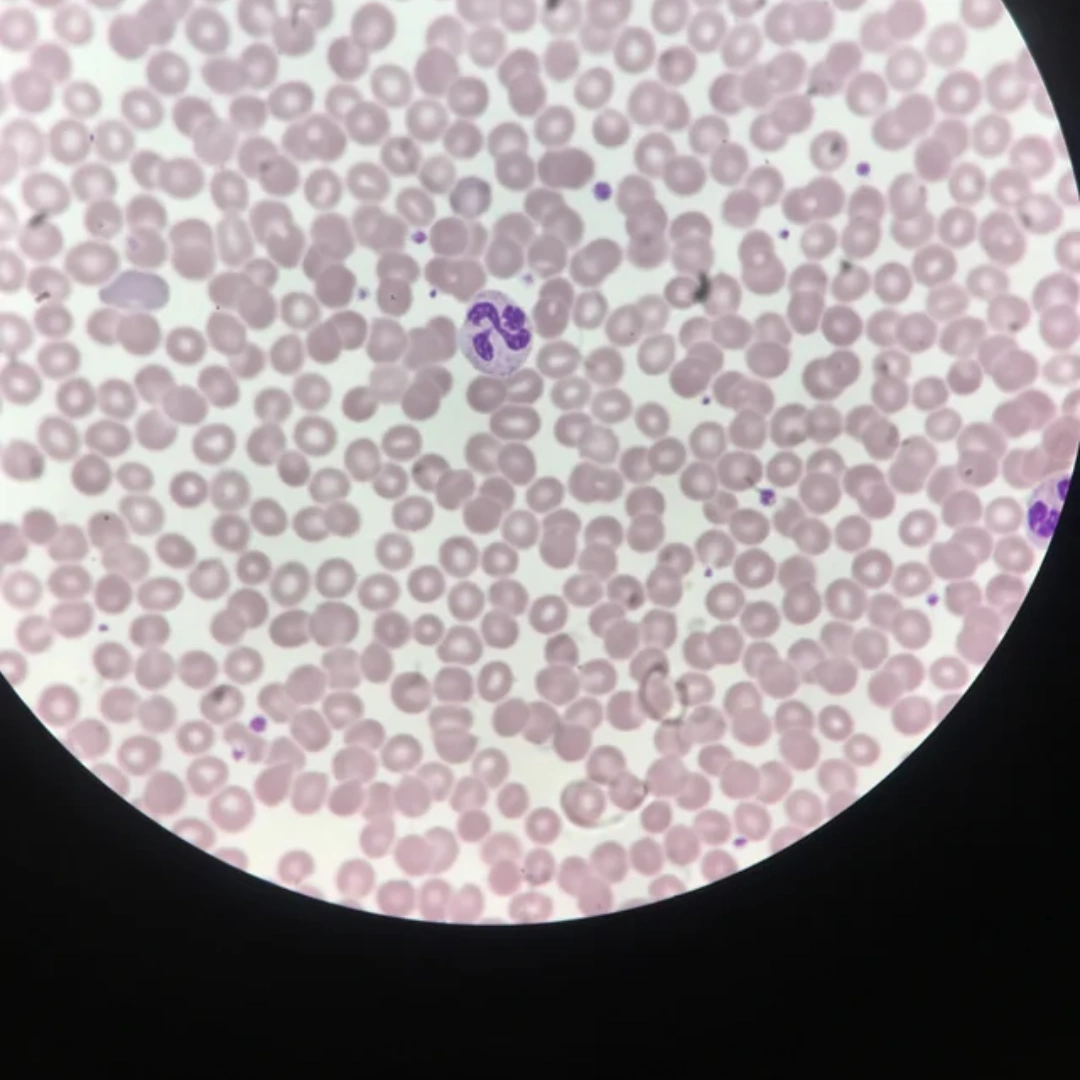
DIFFERENTIAL LEUKOCYTE COUNT, WHOLE BLOOD

Differential Leukocyte Count, Whole Blood
What it is
The Differential Leukocyte Count (DLC), Whole Blood test measures the percentage and relative proportion of different types of white blood cells (WBCs) in the blood. These include neutrophils, lymphocytes, monocytes, eosinophils, and basophils. Each cell type plays a unique role in the body’s immune defense, and variations in their levels can indicate infections, allergic reactions, inflammation, or hematological disorders.
Uses
This test is used to assess the body’s immune response and to help diagnose a wide range of conditions including bacterial or viral infections, parasitic infestations, allergic responses, bone marrow disorders, and certain blood cancers. It is often ordered as part of a Complete Blood Count (CBC) with differential.
Symptoms That May Lead to the Test
Doctors may recommend this test if you experience unexplained fever, persistent fatigue, recurrent infections, swollen lymph nodes, night sweats, weight loss, or allergic symptoms such as wheezing and skin rashes. It is also indicated in routine health checkups and for monitoring patients with chronic illnesses or immune disorders.
Abnormal Results
High Neutrophils (Neutrophilia): Suggests bacterial infection, inflammation, or stress response.
High Lymphocytes (Lymphocytosis): Indicates viral infection, chronic inflammation, or certain leukemias.
High Monocytes (Monocytosis): May indicate chronic infections (e.g., tuberculosis) or autoimmune disorders.
High Eosinophils (Eosinophilia): Common in allergies, asthma, or parasitic infections.
High Basophils (Basophilia): May be associated with allergic reactions, chronic inflammation, or myeloproliferative disorders.
Low Counts: A decrease in any cell type can signal bone marrow suppression, immune deficiency, or drug-induced suppression.
Risks
The test requires a standard blood sample. Risks are minimal and may include slight pain, bruising, or dizziness at the puncture site. These are temporary and uncommon.

Reviews
There are no reviews yet.